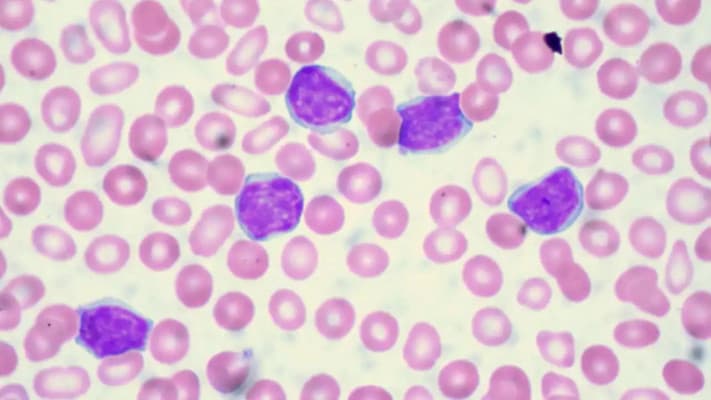
Bilim Adamları Lösemi İçin Çığır Açan Bir Tedavi Yöntemi Geliştirdi

Sağlık
Davranışların Dalgalı Sürümü: Deliryum Nedir?
FFurkan Toprak
·31 Ocak 2024·3 dk






<h2>Genetik bir hastalık olarak bilinen Herediter Anjioödem tedavi edilmediği takdirde hastanın hayatını olumsuz etkileyebiliyor. Farklı semptomları beraberinde getirmesi nedeniyle ölümcül ya da acil müdahale edilmesi gereken durumlar da oluşturan bu hastalığın yakın takip edilmesi gerekiyor. Peki, Herediter Anjioödem nedir, belirtileri nelerdir? Herediter Anjioödem hastalığına hangi bölüm bakar?</h2>






<p>Dünyaca ünlü bilim insanı Dr. Canan Dağdeviren, MIT (Massachusetts Institute of Technology) Media Lab'deki ekibiyle birlikte, meme kanserinin teşhisinde çığır açabilecek bir buluşa imza attı. Dağdeviren giyilebilir meme ultrason cihazı ve bilim hayatı ile ilgili sorularımızı yanıtladı.</p>